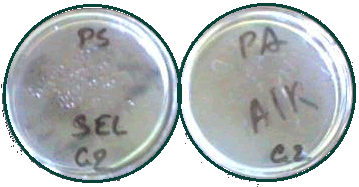

L’UTILISATION DU SEL DANS SON ENVIRONNEMENT

|
DES
FAITS : |
|
UNE
HYPOTHESE : |
Pour
trouver une réponse à cette première hypothèse, nous avons effectué deux
expériences qui nous a apporté une réponse sûre.
Expérience n°1:
On
a d’abord pris 2 harengs juste pêchés et donc encore frais. On place
un des harengs dans un bac et on le recouvre de sel. On place l’autre
dans un autre bac a l’air
libre(1)
|
|
|
|
|
|
Le
but de l’expérience
est de démontrer
que le sel a une action sur le poisson que l’on
a recouvert. Pour ce faire, on laisse les 2 poissons à l’air
libre pendant une semaine, sans y toucher.
A
la fin de la semaine, on sort les deux harengs. Afin de comparer leur état, on
les dissèque :
|
|
|
Sur le premier poisson, c’est à dire celui que l’on
a laissé à
l’air
libre (2), on remarque (d’abord
à
l’odeur
! ! !), qu’il
s’est
décomposé.
Sur
le second poisson (3), celui que l’on avait recouvert de sel, on
observe un dessèchement. La seule différence entre les deux poissons étant le
sel, on peut en déduire que c’est celui-ci qui a agit sur ce poisson.
On remarque qu’il
est apparu un peu d’eau
au fond du bac. C’est
donc le sel qui a "aspiré" l’eau
contenue dans le hareng.
C'est " l'eau libre " contenue dans le poisson qui est passée
dans le bac renfermant le sel.
Si l’eau
favorise la multiplication des bactéries, en absorbant l’eau
du poisson, le sel empêcherait
donc la décomposition
de celui-ci. C’est
grâce
à ce pouvoir d’absorption
qu’il
conserverait les aliments.
Expérience n°2: RECHERCHE BACTERIOLOGIQUE
BUT
: On cherche à prouver que le sel, en enlevant l’eau,
restreint la prolifération bactériologique
Si le sel empêche la prolifération des organismes, alors on doit pouvoir mettre
en évidence l'absence des microbes dans les tissus du poisson placé dans le
sel.
Protocole expérimental
Préparation de la suspension mère : On prend un morceau du poisson
précédemment conservé dans le sel et on le place dans un flacon contenant 10 ml
d’eau
stérile.
On agite pour obtenir une solution bien homogène .On refera la même
préparation
pour le poisson laissé à
l’air
libre
Illustration

Une
fois l'opération de dilution , on prend à l’aide
d’une
spatule de Ghon de l’eau du dernier flacon. On en met
alors dans une boite à Pétri avec de la Gélose.
On
laisse reposer.

UNE SEMAINE PLUS
TARD...
|
Pour le
poisson conservé dans le sel, tout est normal, il n'y a pas de présence
importante de bactéries. |
|
|
Pour le
poisson conservé à l'air libre, donc humide, on observe une culture
bactériologique plus nette. |
REMARQUES : Les manipulation ont été effectuées dans des
conditions aseptiques .Les erreurs sont toujours possible mais la forte
proportion de boites restées stériles dans les milieux n°1 laisse penser
qu'aucune contamination extérieures n'a eu lieu .
CONCLUSION
On
sait que les bactéries se sont moins bien développée
dans le poisson conservé dans le sel. Or, on sait aussi que le poisson conservé
était desséché (exempt d’eau),
les bactéries se sont donc moins développées en absence d’eau.
Le
sel conserve donc les aliments grâce à ses propriétés de rétention d’eau.
Charrier Sébastien, Fesseau Yohann, Coue Pierre, Mathieu Carayol